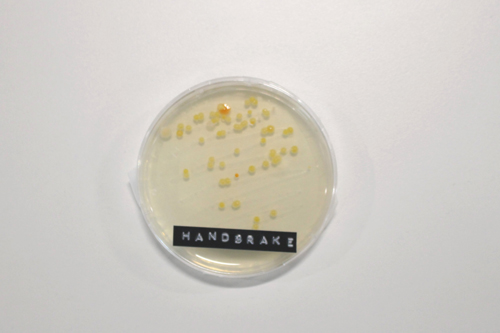
Những vị trí bẩn nhất trên ôtô ít người để ý nhung vi tri ban nhat tren oto it nguoi de y

Chọn ngẫu nhiên mẫu xe từ một tài xế người Anh thường mang theo chú chó cưng, các nhân viên của Motorpoint tiến hành dùng bông tăm tiệt trùng, lau bề mặt khoảng 20 vị trí trong xe. Mỗi mẫu vật được đặt vào một đĩa chứa hóa chất, sau đó để trong môi trường có nhiệt độ lý tưởng cho các vi sinh vật phát triển.
![]() |
| Dùng bông tăm lau bề mặt chốt cài dây đai an toàn... |
![]() |
| ... sau đó đặt mẫu vật lấy được vào đĩa tròn. |
Kết quả cho thấy những vị trí bẩn nhất trong xe hơi như sau:
1. Cốp xe
![]() |
| Vi sinh vật phát triển từ mẫu lấy từ khoang chứa đồ của xe hơi thường xuyên để thú cưng bên trong. |
Với những người thường xuyên để thú cưng ở khoang chứa đồ, cần chú ý đến vị trí này và thường xuyên vệ sinh bởi người bạn bốn chân có thể là nguyên nhân mang những mầm bệnh từ ngoài vào trong xe.
2. Không gian để chân ở vị trí tài xế
![]() |
| Hình ảnh mẫu vật lấy từ vị trí không gian để chân của tài xế. |
Vị trí thường xuyên sử dụng do sự lên xuống của tài xế là một trong những nơi bẩn nhất trên xe hơi. Nếu dùng thảm lót chân, chủ xe nên thường xuyên vệ sinh phụ kiện này để giữ cho không gian sạch bên trong xe.
3. Chốt cài dây đai an toàn
![]() |
| Vi sinh vật phát triển từ mẫu lấy từ nút gài dây đai an toàn. |
Một bộ phận thường xuyên sử dụng khác trên xe hơi là chốt cài dây đai an toàn cũng chứa nhiều mầm mống không tốt.
4. Phanh tay
![]() |
| Mẫu lấy từ phanh tay. |
Phanh tay là một trong những vị trí cần lưu tâm khi tiến hành vệ sinh nội thất vì tần suất sử dụng nhiều.
Ngoài những vị trí cho thấy tiềm ẩn vi khuẩn, mầm bệnh, thí nghiệm của Motorpoint liệt kê một số vị trí "sạch" nhất trên ôtô:
![]() |
| Mẫu lấy tại vị trí mép vô-lăng. |
![]() |
| Mẫu lấy tại gương chiếu hậu. |
![]() |
| Mẫu lấy tại cần sang số. |